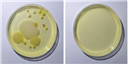
noname015.png

2021년11월15일-19일
서울대, 정전분무, 인공지능, 요소수, 발자크, 로댕
by
Nov 12. 2021

과학분야
⨀ 데이터, AI가 이끄는 과학기술계의 패러다임 전환(한국과학기술연구원)
- 앨리시움이 현실이 될 수 있다니
⨀ 물방울로 초미세먼지 정화한다(사이언스타임즈)
- 청정한 공기도 이제는 무료가 아니다
경제분야
⨀ '수입처 다변화' 중요성 거듭 일깨운 '요소수' 품귀 사태(한겨레)
- 모든 계란을 한 바구니에 담지 말라는 경제의 기본이라는데
⨀ 물류대란 비상등 켜진 요소수 품귀, 만반의 대비를(서울신문)
- 만반의 대비를 하려면 원인을 알아야지, 정부가 대란의 원인인가
미술분야
⨀ 로댕의 모순된 선택(동아일보)
- 시대를 뛰어넘는 예술품은 당대에 인정을 못 받아왔다나
사회분야
⨀ "조국 이어 오징어게임까지..." 학교 이미지 추락에 서울대 한숨(조선일보)
- 머리 좋고 공부 잘하면 인성도 좋을 거라는 환상은 이미 깨진지 오래
⨀ 누가 지방에 사는가(경향신문)
- 사람들로 붐비고 부때끼는 것이 적은 지방이 내겐 좋다